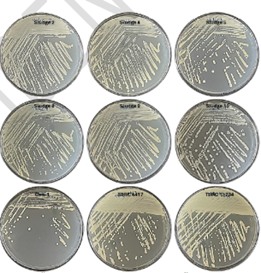

Innovation and Customer Stewardship
Innovation & Customer Stewardship
Challenges, Risks,
and Impacts
Thaioil Group is currently undergoing a business transformation, reshaping its portfolio to focus on high-value, low-carbon businesses. This transition aligns with the 2S1P strategic plan to create growth opportunities and enhance the organization’s future value. Furthermore, the Company has expanded its footprint into high-potential markets across Southeast Asia and South Asia to increase market share and broaden its customer base. These efforts are carried out alongside initiatives to build business resilience, mitigate risks, and strengthen long-term competitiveness. environmental issues, such as climate change and plastic waste management, pose significant challenges.
As a leader in the Thai energy industry, Thaioil Group prioritizes research and development (R&D) in technology and innovation. This focus encompasses both manufacturing processes and the development of high-value products (HVP) to adapt to and meet the evolving demands of both domestic and international markets. By emphasizing production efficiency and creative high-value product development, the Company aims to reduce operational costs while generating new revenue streams. This approach not only builds a competitive advantage but also responds to changing customer needs, particularly regarding product quality and safety.



Thaioil Group has promoted the importance of corporate innovation since 2022 by integrating innovation as one of its corporate values. Furthermore, the Company was initially assessed the level of corporate innovation and achieved Level 3 (Challenging Level) out of a total of 5 Levels. Thaioil Group is committed to advance its corporate innovation from Level 3 (Challenging Level) to Level 4 (Proficient Level) by 2026. This progression will position the Company on par with other leading companies both domestically and internationally.
Targets
Thaioil Group is committed to advancing the status of innovation-driven organization from Level 3 to Level 4 by 2026, progressing from its current Level 3 standing. Level 4 is defined by the active research and development of innovative products or services that deliver significant business impact. Achieving this ambitious goal requires cross-functional collaboration to drive innovations that meet both current and future customer needs. To ensure success, Thaioil has established a year-by-year roadmap as follows:
2024: Emphasizing on rolling the creative ideas into practices to create prototype for testing with users or customers, gathering feedback from those, and developing those prototypes into products or services that serve their needs. In this year, the level of corporate innovation was reassessed to consider the changes over the past two years.
2025: Taking the results of a corporate innovation maturity level to develop, improve, and enhance the employee’s capability to elevate the Company’s status of innovation-driven organization to Level 4 (Proficient Level) by 2026 as defined. During this phase, new products will begin entering the market, fulfilling the criteria for a Level 4 innovative organization.
2026: Conduct the third organizational innovation assessment.
Level of Innovation
Target 2026
4 (Proficient Level) (out of 5 Level)
level
Thaioil Group prioritizes customer satisfaction with both the Company’s products and services, starting from order reception and continuing throughout the management process to ensure that customers receive complete, accurate, and timely products. The Company proactively handles complaints and closely follows up to resolve the issue. Furthermore, the Company collaborates with customers to develop products to meet their specific needs. This enables the Company to adjust marketing strategies appropriately and grow alongside partners sustainably.
Maintain Thaioil Group’s customer engagement score
Target 2025
93
Percentage
Customer issue resolved
Target 2025
90
Percentage
Management Approach and Performance
Innovation Management
Management Approach
In 2025, Thaioil Group established a Corporate Key Performance Indicator (KPI) for innovation to strengthen long-term business resilience by defining five progressive levels of achievement. Level 1 focuses on prioritizing innovation projects and evaluating prototypes to determine the most suitable paths for further development, while Level 2 and 3 require the development of at least 5 and 10 prototypes, respectively, that have received positive feedback from users. Progressing further, Level 4 is achieved when at least one new product is ready for market launch and has successfully undergone customer validation. At the highest stage, Level 5 requires either having at least two new products ready for market with confirmed customer acceptance or having at least one new product that has already begun generating revenue for the Company.
Corporate innovation goals have been comprehensively cascaded to all 37 departments across the Company. These innovation projects are categorized into three primary types: Support, which focuses on enhancing organizational effectiveness; New Revenue Stream, which identifies new business opportunities to increase revenue and competitive potential; and Operational Excellence, aimed at elevating operational efficiency and production quality. Every project is evaluated based on two dimensions—Newness and Impact—to ensure high-quality outcomes. The core focus is on transforming ideas into prototypes and testing them with actual users or customers to gather feedback for continuous development until they become viable market-ready products or services. As a result, in 2025, employees across all 37 departments successfully developed 49 prototypes from their respective innovation projects and received positive user feedback. These initiatives represent a total potential benefit of 465 million Baht per year. Furthermore, out of 10 new product development projects, 5 products have already been launched to the market and are generating actual revenue, allowing the Company to achieve the highest level (Level 5) of its corporate innovation goals this year.
Furthermore, these operations are aligned with the goal of elevating the Company’s innovation maturity from Level 3 (Challenging) to Level 4 (Proficient) out of 5 levels by next year. This progression focuses on developing commercialized new products that are market ready. Thaioil plans to conduct another organizational innovation assessment in 2026 to reflect the continuity of development and its readiness to effectively translate innovation into commercial success. By fostering a culture of creativity among employees at all levels, the Company aims to continuously advance its innovation capabilities, reaching a standard comparable to leading domestic and international innovative companies.
Innovative Culture
Approach to build internal corporate innovative culture
Thaioil Group has continuously encouraged employees to create innovations collectively and fostered continuous learning opportunities in the field of innovation. In 2025, the Company organized activities to enhance employees’ awareness of the importance of innovation as follows:
i-LEAD Project
In response to the Company’s business strategies, Thaioil Group has focused on creating new innovations as a cornerstone to foster sustainable business growth. Hence, the Company places importance on “innovation” by prioritizing and empowering employees to develop creative solutions and invent new ideas and innovations to deliver value-added products and services in the future.
Thaioil Group has systematically promoted the internal innovation culture through the “i-LEAD” behaviors. The behaviors are specified through a screening process by the employee representatives from all levels. The project aims to ensure employees can clearly understand, remember, and embody these behaviors in alignment with the organization’s goals. In 2024, the Company elevated its efforts by encouraging employees to consistently integrate these behaviors into their work routines, fostering a habit of innovation. This initiative supports the company’s journey toward becoming an innovative-driven organization through a variety of activities, as detailed below:
Organized this activity to promote knowledge of innovation through E-learning on the Thaioil Academy platform which is an online learning platform of Thaioil Group. This encourages employees to learn about principles, approaches, and concepts regarding innovation from selected innovation experts to serve as a foundation and inspiration for employees to create innovations.

TOP Class to be Innovative Squad 101 (E-Learning Challenge)
Activities to encourage employees to appreciate i-LEAD behaviors are part of the Spark Joy application initiative under the “Suk Chuen Chom” program. This initiative allows employees at all levels, including executives, supervisors, and colleagues, to express appreciation, recognition, and encouragement when i-LEAD behaviors are demonstrated.

Recognition of i-LEAD Behaviors through the "Suk Chuen Chom" Program
The Enhancement of Innovation Knowledge for Employees
Thaioil Group encourages the employees to become quality innovators by raising awareness of the importance of innovation, providing knowledge enhancement for continuous development, and creating inspiration for innovation through the following activities:

TOP Innovation E-newsletter

TOP BCG Updates

Innovation Talk
Thaioil Innovation Awards 2025
In 2025, Thaioil Group compiled and evaluated a total of 73 innovation prototype projects from all departments through a dedicated judging committee, ultimately selecting 10 outstanding projects to receive the 2025 Innovation Awards. The top honor for the best innovation project was awarded to “Next Gen Document Supervision” by the Asset Development Function. This project leverages the power of Artificial Intelligence (AI) and mathematical modeling to develop a tool for removing unwanted data or symbols from documents with over 97% accuracy. The system successfully processed more than 1.5 million document pages within just two and a half months—a speed 16 times faster than manual processing—resulting in a significant reduction in contractor expenses totaling 56 million Baht.
On November 5, 2025, the Company hosted the “Innovation and Learning Day 2025,” an event filled with various activities focused on organizational learning and innovation. The Chief Executive Officer and President presided over the ceremony to present awards to outstanding innovation projects, serving as a significant morale booster for all employees to continue their creative and innovative pursuits for the Company.

Thaioil Innovation Awards 2024

Thaioil AI Hackathon 2025
Thaioil Group prioritizes the continuous development of its personnel through the Thaioil AI Hackathon 2025, an initiative designed to empower employees to apply Artificial Intelligence (AI) to create tangible benefits for the organization. This program was organized in collaboration with a partner experienced in hosting hackathons for Thailand’s leading corporations, featuring a premier coaching team of national experts in AI, business strategy, and professional pitching. The project attracted 73 participants forming 22 teams from across the entire organization, all of whom participated in specialized workshops designed to sharpen their innovative capabilities as follows:
AI Business Canvas Workshop: Focused on the strategic framework of applying AI to business contexts led by:
- Jessadakorn Smithiattagorn (Ton): CEO of Data Wow, a premier Data & AI Consulting firm.
Vibe Coding Workshop: Focused on transforming innovative ideas into tangible solutions, mentored by a team of experts:
- Piyarit Ittichaiwong (Dr. Ar): A medical professional from Siriraj Hospital currently pursuing a PhD in Medical AI at King’s College London, UK.
- Natchanon Yongsatianchot: A professor from the Department of Electrical and Computer Engineering at Thammasat University, specializing in Artificial Intelligence (AI) and Affective Computing.
- Supasate Worathammathorn: An engineer and researcher in Computer Vision and Artificial Intelligence from King Mongkut’s University of Technology Thonburi.
Following the intensive training sessions, participating teams applied their knowledge to transform their ideas into tangible prototypes during the Hackathon. Throughout this process, they received close mentorship and learned directly from external industry experts. The competition culminated in the final judging, with the winners officially announced on November 26, 2025.
The winning title was awarded to Team Synapse, which utilized AI-driven Computer Vision to manage over 3,000 engineering pipe support components. Once fully developed, this prototype is projected to drastically reduce processing time from “several months” to just “a few minutes,” generating a potential benefit valued at over ten million Baht. As a reward, the winning team will participate in a study trip to visit world-leading innovation and AI technology companies abroad, further expanding their expertise and gathering inspiration to drive future innovative value for Thaioil.
Approach to build innovative collaboration with external organizations
2025 marks a pivotal year for the initiation of new research and development (R&D) projects, alongside the concrete implementation of R&D plans. This comprehensive approach encompasses human resource management, research management, the advancement of prototypes, collaborative testing with customers, and the successful transition of products into commercial production processes.
These efforts are organized under a structure consisting of six Centers of Excellence, which include:
- Crude Excellence Center
- Catalyst & Adsorbent Excellence Center
- AI/Robotics Solution Provider
- High Value Product/High Value Business
- Polymer & Olefin Derivatives
- Sustainability & New Business
The six Centers of Excellence are dedicated to fostering collaborative research with academic and public agencies to develop innovative products that cater to the evolving needs of both existing and potential customers. This is accomplished through a highly efficient cross-functional team approach, ensuring seamless coordination across departments. In 2025, the Company initiated 24 research and development projects, consisting of 17 newly initiated projects, 7 ongoing projects, and 7 successfully completed projects.
Besides the collaboration with educational and government agencies, Thaioil Group has expanded the partnerships to develop new products with the research and development units of the private sector, such as Siam Pro (Thailand) Co., Ltd., which specializes in the design and formulation of surfactants for various industries, including food, livestock, healthcare, and hospitality, as well as the household sector. Their expertise spans a wide range of products—from dishwashing liquids, laundry detergents, and floor cleaners to disinfectants—while providing comprehensive Original Equipment Manufacturer (OEM) services.
In addition, in 2025, the research and development projects completed through collaboration with academic institutions and government agencies include:
- The project to develop a robotic system for cleaning the heat exchanger pipes of oil heaters in the oil refining process: Developed in collaboration with the Vidyasirimedhi Institute of Science and Technology (VISTEC), this project features a prototype robot capable of climbing and cleaning 5-inch and 6-inch pipes at heights without the need for scaffolding. This innovation significantly reduces safety risks associated with working at heights and in confined spaces. The prototype was initially tested during the Company’s recent major maintenance period, demonstrating its potential to enhance cleaning efficiency and reduce manual labor intensity. Furthermore, effective cleaning improves furnace energy efficiency and contributes to lower CO2 emissions within the production process.
- The project to test the efficiency of Activated Carbon in removing Volatile Organic Compounds (VOCs) and Benzene from the waste gases of wastewater treatment systems: This project is a collaborative initiative with The Petroleum and Petrochemical College (PPC), Chulalongkorn University. It involves testing the efficiency of activated carbon under the actual operating conditions of the refinery. The objective is to utilize the test results to inform the selection of the most effective and cost-efficient type of activated carbon that can appropriately handle the volume and specific properties of Thaioil’s waste gas. Furthermore, these findings enhance confidence in material selection and support the refinery’s commitment to sustainable environmental compliance.
- The project to high-quality Volatile Organic Compound (VOC) adsorption products for industrial tank and equipment cleaning: This project is a collaborative research initiative with The Petroleum and Petrochemical College (PPC), Chulalongkorn University, to develop a surfactant-based product designed to adsorb residual VOCs in equipment, specifically for use in wet scrubber systems. Laboratory testing has revealed that the prototype is three times more effective at reducing VOCs than the products currently in use. The project is currently in the planning phase for on-site field testing within the refinery.
Product Innovation
Developing new products, increasing the value of existing products, or developing high value products rely on the collaboration of research and development with internal and external partners. These partnerships are essential for identifying new product opportunities and refining production processes to meet specific market demands, partnering with educational institutions to explore technology and business trends for the benefit of new product development, as well as collaboration with research and development units of the private sector to jointly develop products that genuinely respond to market demands.
Examples of key Thaioil Group’s product innovation in 2025 are as follows:

Rubber Process Oil (RPO)
The development of specialized Rubber Process Oil (RPO) with low levels of Polycyclic Aromatic Hydrocarbons (PAHs) addresses the demands of the tire industry while increasing the product value for Thai Lube Base Public Company Limited. By innovating formulations with optimized properties, such as viscosity and polarity, while reducing PAH levels to be environmentally friendly and compliant with European Union (EU) regulations, this project marks a significant milestone. It not only reduces reliance on imports but also enables Thaioil Group to expand its market presence from conventional lubricants manufacturing into the tire manufacturing. This product has been successfully commercialized since February 2025.

Hydrocarbon Decontamination Chemical
The product is a surfactant designed for industrial use to remove hydrocarbon stains or oils and volatile organic compounds (VOCs) remaining in equipment in the refinery and petrochemical industries, ensuring levels below 500 parts per million (ppm) before the equipment can be opened and inspected. The research team has developed this project in collaboration with The Petroleum and Petrochemical College (PPC), Chulalongkorn University, since 2024. In 2025, two new products were launched: DBTX10, ideal for cleaning high-aromatic hydrocarbons, and DGasoline, suitable for general hydrocarbons such as gasoline and crude oil. The formulas for both products have been filed for petty patent protection and have successfully passed prototype testing and commercial-scale implementation within the organization, involving more than 8 tanks and 3 units throughout 2025.
Assessment results indicate that these products outperform existing industrial chemicals in removing stains and reducing vapors. They help minimize chemical usage, waste generation, and working hours, while being non-corrosive and having no impact on wastewater treatment systems. Thaioil plans to expand these products to external markets in 2026.

Waterless Hand Cleaner
The product is a surfactant-based formula designed to remove dirt such as oils, hydrocarbons, grease, ink, and other substances from the skin, including palms and arms, without the need for repeated rinsing with water. This research project is a collaboration with InnoXcellar Co., Ltd., where a prototype product was developed that effectively cleans while being gentle on the skin and not causing allergic reactions. The product has been tested and certified by dermatologists from recognized institutions. Currently, the product from this project is registered with the Food and Drug Administration (FDA) and has successfully been filed for petty patent protection. Sample products have been distributed to employees in maintenance, engineering, and production units, as well as external customers, to collect feedback. This data will be used to refine the product before its market trial and official commercial launch in 2026.

Mild Surfactant Ingredient for Personal Care Products
Specialized surfactants developed under a collaboration with Suan Dusit University (SDU) to meet the needs of customers in the personal care industry, specifically for cleansing products. The key highlights of this innovation include exceptional mildness, high cleaning efficiency, and the ability to produce dense, fine, stable, and transparent foam. Marketed under the trade name PureSurf™ Mild, this specialized surfactant formula is protected by a petty patent and has successfully passed irritation testing by dermatologists from a standardized institute. In 2025, the research team focused on scaling up production from laboratory to industrial levels. Product samples were distributed to customers for feedback, alongside the development of formulation guidelines for specific applications, such as feminine hygiene products, baby shampoo, and dog shampoo, to serve as a guide for potential clients. Additionally, PureSurf™ Mild was showcased as a Thaioil Group innovation at In-cosmetics Asia 2025, where samples were distributed to pave the way for marketing expansion in 2026.

Metal Cleaners
High-performance metal cleaners designed for maintenance tasks to eliminate various contaminants—such as lubricants, hydrocarbons, scale, rust, and residues from equipment assembly—without damaging or corroding metal surfaces. This research project focuses on developing a new generation of metal cleaners using surfactants specifically optimized for heavy-duty metal cleaning and diverse environmental conditions. The goal is to replace current products that may contain corrosive agents, cause user irritation, or impact the environment. The research has resulted in two distinct prototype formulas:
Neutral Formula (pH 7–9)
Designed for general cleaning of light-to-moderate stains. It is non-destructive to metal and ideal for alloys sensitive to alkalinity, such as aluminum, brass, and galvanized steel, as well as parts requiring high surface safety.
Alkaline Formula (pH 12–13)
Developed for heavy-duty tasks, including used engine oil, stubborn grease, heavy sludge, and carbon deposits from welding. This formula utilizes specialized surfactants that remain stable in high-alkaline conditions to effectively break down tough stains.
Both prototypes are currently undergoing performance testing in maintenance and engineering workflows. Preliminary results show that their cleaning efficiency is comparable to current commercial products while offering superior material compatibility, reducing the risk of residues or spotting after washing. Thaioil plans to register these products with the Food and Drug Administration (FDA) and officially launch them to the market in 2026.

Laundry Detergent for Washing Oil-Stained Clothes
D-Oil X, a heavy-duty laundry detergent, has been specifically designed to address the challenges of cleaning workwear contaminated during refinery operations. It effectively targets stubborn stains such as crude oil, hydrocarbons, grease, soot, and asphalt—contaminants that standard laundry products typically fail to remove. The prototype formula features a specialized blend of high-performance surfactants, builders, and specialized agents (soil-release and anti-redeposition) to break down stains and prevent them from re-attaching to the fabric. Developed in collaboration with Siam Pro (Thailand) Co., Ltd., the project focuses on cleaning the uniforms of personnel in production, maintenance, and engineering units. Preliminary testing conducted with the HR Services Department (responsible for laundry management) indicates that its stain-removal efficiency is superior or equivalent to existing commercial products, receiving high satisfaction from actual users. Currently, sample products have been distributed to employees and contractors during the 2025 QSHE Day to gather further feedback. Thaioil plans to register the product with the Food and Drug Administration (FDA) and proceed with a full market launch in 2026.
Process innovation can be classified into the development of production processes, operational processes, or product development processes. Examples of key Thaioil Group’s Process Innovation in 2025 are as follows

Microbial waste in wastewater treatment systems
In collaboration with the National Nanotechnology Center (NANOTEC), NSTDA, this project focuses on studying and developing a high-efficiency liquid metal catalytic process to capture and convert CO2 into carbon materials. By utilizing simulated flue gas that mimics the actual emissions from Thai Oil Public Company Limited, the project aims to create opportunities for developing suitable technologies that can be integrated into the Company’s processes to reduce CO2 emissions in the future.
Microbial waste in wastewater treatment systems
This project is a collaboration with the National Center for Genetic Engineering and Biotechnology (BIOTEC), NSTDA, with the goal of supporting CO2 emission reduction. The study focuses on adding value to microbial sludge from wastewater treatment systems as an alternative to disposal through incineration. The project initiated with the extraction and isolation of various enzymes, as well as the screening of potent microorganisms capable of enzyme production directly from the sludge. These microorganisms serve as inoculants for simultaneous sludge degradation and enzyme production. Research findings indicate that certain microorganisms can efficiently degrade sludge and convert it into Lipase and Protease enzymes. Additionally, some strains exhibit the potential to produce other high-value substances, such as Biosurfactants, Biohydrogen, and Bioplastics. This highlights the significant opportunity to develop industrial-scale technologies for microbial sludge utilization in the future.

Soil nutrition
This research project investigates the feasibility of improving and processing sludge from raw water treatment ponds into soil conditioners or potting soil. The primary objectives are to add value to waste materials, minimize the volume of sludge requiring disposal, and develop planting material with optimal properties for plant growth.

Carbon fiber from polyethylene
This research project investigates the creation of advanced materials from basic products. Currently, the high cost of carbon fiber limits its application to industries requiring materials with exceptional strength. In collaboration with the National Nanotechnology Center (NANOTEC), NSTDA, this research initiates the conversion of polyethylene fibers through a specifically developed process to transform them into carbon fiber. The results of this process have yielded carbon fiber with a satisfactory level of structural strength.

Crude Compatibility Prediction Model Improvement
This research project focuses on the development of a web application platform that integrates machine learning and computer vision to automatically predict crude oil blending compatibility risks. The system can help minimize the risk of fouling in heat exchangers and significantly reduces operational costs within the crude oil refining process.

RHCU Pilot Plant (Residue Hydrocracking)
The RHCU Pilot Plant is a simulation facility for the Residue Hydrocracking Unit (RHCU) within the Clean Fuel Project (CFP). Its primary objective is to test and select optimal crude oil blends and process variables for the RHCU unit. The results are utilized in production planning to maximize yields and efficiency.
In 2024, the Thaioil team, in collaboration with the RHCU Pilot Plant designers and installers, successfully completed the commissioning and performance verification of the equipment according to the plan.
In 2025, the RHCU Pilot Plant commenced testing on the same crude oil blend samples previously sent for testing in the United States. The plant will continue to conduct tests on various crude oil formulas designated for the RHCU production process.
Thaioil Group’s clean technology innovation includes the development and transition towards alternative fuels, exploring and studying new energies aims to reduce or eliminate greenhouse gas emissions from combustion (Low-Carbon Energies) and conducting studies on sustainable aviation fuel. Additionally, the Company is actively engaged in pollution prevention and control, with a strong focus on air quality management through carbon capture and storage (CCS) initiatives. These efforts reflect the Company’s commitment to pioneering environmentally responsible solutions and driving the energy sector towards a low carbon future. Examples of Thaioil Group’s ongoing low carbon technology innovation and initiatives include:

Alternative Fuels
- Sustainable Aviation Fuel (SAF) projects utilizing commercially developed technologies as follows:
- Utilizing HEFA (Hydrotreated Esters and Fatty Acids) technology to produce eco-friendly aviation fuel from used cooking oil, palm oil mil effluent (POME), Palm fatty distillate (PFAD) and animal fats, in collaboration with the PTT Group.
- Employing ATJ (Alcohol to Jet) technology to convert bio-based alcohols, like ethanol, into cleaner aviation fuel in collaboration with our strategic partners. This will help reduce the aviation sector’s carbon emissions.
- Using Co-Processing Technology to produce SAF by co-processing renewable feedstock within our existing hydroprocessing units. In addition, the Company is currently studying regulations, technology readiness levels, and raw material procurement to ensure a reliable and sustainable supply of Used Cooking Oil (UCO), and exploring alternative waste feedstocks, such as POME (Palm Oil Mill Effluent), PFAD (Palm Fatty Acid Distillate), and other waste feedstocks.
- The New Energy Exploration Project aims to reduce or eliminate greenhouse gas emissions from combustion by focusing on clean hydrogen and its derivatives, such as ammonia, as well as other low-carbon fuels produced from clean hydrogen. The project includes preliminary studies and assessments of key factors, such as costs, technologies, strategically significant location along the entire supply chain. Additionally, the project explores other alternative energy sources, such as biofuels, for alternative energy production to reduce reliance on fossil fuels. Furthermore, the Company is evaluating the feasibility of investing in reforestation projects to generate carbon credit, which would provide environmental benefits and support its long-term sustainability goals.

Bio-based products

Carbon Capture and Storage (CCS)

Energy Efficiency Projects
The Energy Efficiency Projects aim to reduce fuel consumption and improve production efficiency, contributing to the Company’s Net Zero GHG emission and long-term sustainability targets, as well as contributing towards operating cost savings.
In 2024, there were 39 energy efficiency improvement projects, resulting in a total energy consumption 494,794 gigajoules, equivalent to 28,985 tons of carbon dioxide equivalent, and 223 million THB of cost savings from the total of 189.62 million THB of investments
2025
Performances
Vel pretium dolor tellus id purus felis tellus cursus. Amet turpis vel enim aliquet maecenas. Egestas nulla urna suspendisse cursus aliquam mauris facilisis.

Customer Stewardship and Product Quality Management
Management Approach
This year, Thaioil Group continues to advance its commitment to delivering superior customer experiences, guided by the “Partner for Life” strategy which treats customers as cherished family members. The Company aims to elevate service standards and foster development projects that drive stable and sustainable mutual growth. The Company has fortified the quality and safety of its products and services to ensure full compliance with international laws, regulations, and standards. Furthermore, it has comprehensively integrated ESG (Environment, Social, and Governance) principles into its operational processes. Throughout the year, Thaioil Group has placed significant emphasis on systematic customer feedback, utilizing in-depth data analysis to drive continuous improvements in service and product quality. By enhancing responsiveness and operational efficiency, the Company seeks to strengthen customer confidence, satisfaction, and long-term engagement, which serve as the essential foundation for sustainable future growth.

In 2025, Thaioil Group continued to implement the “Partner for Life” strategy to support customer stewardship in three aspects as follows:
- Partner for Innovation: Leveraging Innovation and Digital Technology to Enhance Operational Efficiency In the annual customer satisfaction and engagement survey, Thaioil Group conducted in-depth analyses and collaborative brainstorming sessions with relevant departments. These insights were utilized to further develop and improve product quality for superior service delivery. This year, several projects integrated digital systems to enhance capabilities, such as the optimization of the e-Ordering system (COMNXT) for greater efficiency and the implementation of an automated monthly reporting system for customers. Furthermore, the Company focused on developing new products tailored to meet increasingly diverse customer requirements.
2. Partner for Excellence: Service Excellence
To maintain high service standards in product distribution, Thaioil Group conducts an annual review of its Service Level Agreements (SLA). In 2025, all business units achieved 100% compliance with these established standards. Furthermore, the Company is developing a system to implement an international-standard platform for managing customers’ needs (Voice of Customer: VOC). This tool is designed to enhance efficiency in addressing various customer needs, including purchase inquiries, feedback, after-sales support, and complaint resolution, thereby sustaining high levels of customer satisfaction and engagement. Additionally, the Company continues to facilitate knowledge sharing sessions covering production processes, oil distribution via truck and vessel, market trends, and legal regulations. These sessions are delivered through both online platforms (Microsoft Teams) and in-person seminars at customers’ offices.
- Partner for Sustainability: Promoting Collaborative Efforts with Customers for Sustainable Business
Thaioil Group organized online ESG quizzes to encourage customer engagement in joint corporate social responsibility (CSR) activities. Additionally, the Company held the “Safety and Happy Hour” event, a safety awareness campaign dedicated to customers stationed at the Thaioil Truck Loading Terminal, Sriracha, and petroleum transport drivers. Furthermore, the Company has communicated various corporate policies, such as the No Gift Policy, to reinforce transparency and corporate governance standards. These initiatives aim to foster business relationships that are transparent, sustainable, and professional.
Highlighted Projects
In 2025, Thaioil Group implemented customer relationship programs under the of “Partner for Life” strategy to cultivate and maintain good relationships with customers as follows:
- “COMNXT e-Ordering” Training Sessions: Thaioil Group organized training sessions for its online product ordering system, designed to enhance convenience and streamline the procurement process for customers.
- “TOP Meets Customers” Initiative: This activity serves as a platform for relevant departments to receive direct feedback and suggestions from customers, enabling continuous service improvement and operational efficiency.
- Knowledge Sharing: Organized knowledge sharing sessions to customers both in online and on-site presentations with various topics such as Fundamental of Refinery Process and Business & Refinery Overview. This aims to enhance customers’ knowledge and understanding of the oil refinery industry and market.

Organized cultural promotion activities through the “Cultural Activity” project.

Organized “Safety and Happy Hours” activity for drivers in 2024

Organized knowledge sharing sessions to customers both in online and on-site presentations with various topics

Organized recreational activities for different customer groups
2025
Performances
Through the execution of various initiatives under the “Partner for Life” strategy, encompassing both product innovation and service excellence, Thaioil Group has successfully achieved customer engagement scores that exceed the established targets.

Remark:
(1) CCustomer engagement of Thaioil Group consists of Thai Oil Public Company Limited (TOP), Thai Lube Base Public Company Limited (TLB), and Thai Paraxylene Company Limited (TPX). This survey was conducted by a third-party company that provides customer satisfaction assessment services.
(2) Customer satisfaction of TOP Solvent Company Limited (TOPNEXT International Company Limited) for 2022 has a full score of 5. The survey was conducted by TOP Solvent Company Limited.
(3) Customer engagement of TOPNEXT International Company Limited in 2023-2024 has a full score of 100 percent. The survey was conducted by a third-party company that provides customer satisfaction assessment services.



























































